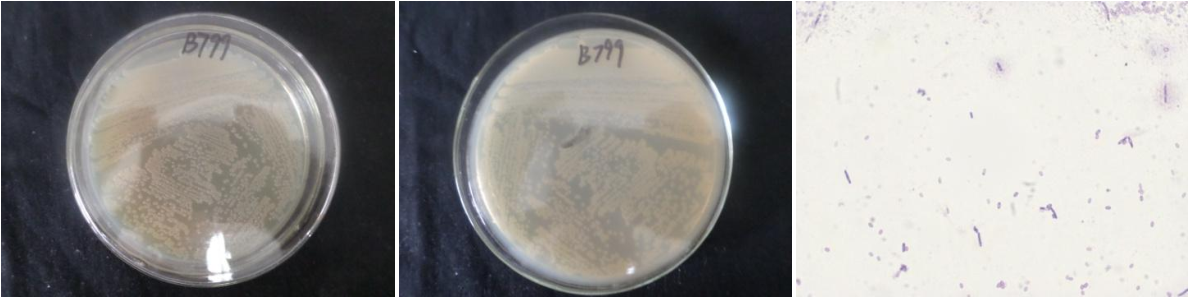

Loading...
| StrainNO | B799 |
| Classification | Brevibacillus |
| 16s rDNA sequence | ATGCAAGTCGAGCGAGTCTCTTCGGAGGCTAGCGGCGGACGGGTGAGTAACACGTAGGCAACCTGCCTCTCAGACTGGGATAACAT AGGGAAACTTATGCTAATACCGGATAGGTTTTTGGATCGCATGATTCGAAAAGAAAAGGCGGCTTCGGCTGTCACTGGGAGATGGG CCTGCGGCGCATTAGCTAGTTGGTGGGGTAACGGCCTACCAAGGCGACGATGCGTAGCCGACCTGAGAGGGTGACCGGCCACACTG GGACTGAGACACGGCCCAGACTCCTACGGGAGGCAGCAGTAGGGAATTTTCCACAATGGACGAAAGTCTGATGGAGCAACGCCGCG TGAACGATGAAGGTCTTCGGATTGTAAAGTTCTGTTGTTAGGGACGAATAAGTACCGTTCGAATAGGGCGGTACCTTGACGGTACC TGACGAGAAAGCCACGGCTAACTACGTGCCAGCAGCCGCGGTAATACGTAGGTGGCAAGCGTTGTCCGGATTTATTGGGCGTAAAG CGCGCGCAGGCGGCTATGTAAGTCTGGTGTTAAAGCCCGGGGCTCaAACCCCGGTTCGCATCGGAAACTGTGTAGCTTGAGTGCAG AAGAGGAAAGCGGTATTCCACGTGTAGCGGTGAAATGCGTAGAGATGTGGAGGAACACCAGTGGCGAAGGCGGCTTTCTGGTCTGT AACTGACGCTGAGGCGCGAAAGCGTGGGGAGCAAACAGGATTAGATACCCTGGTAGTCCACGCCGTAAACGATGAGTGCTAGGTGT TGGGGGTTTCAATACCCTCAGTGCCGCAGCTAACGCAATAAGCACTCCGCCTGGGGAGTACGCTCGCAAGAGTGAAACTCAAaGGA ATTGACGGGGGCCCGCACAAGCGGTGGAGCATGTGGTTTAATTCGAAGCAACGCGAAGAACCTTACCAGGTCTTGACATCCCGCTG ACCGCTCTGGAGACAGAGCTTCCCTTCGGGGCAGCGGTGACAGGTGGTGCATGGTTGTCGTCAGCTCGTGTCGTGAGATGTTGGGT TAAGTCCCGCAACGAGCGCAACCCTTATCTTTAGTTGCCAGCATTCAGTTGGGCACTCTAGAGAGACTGCCGTCGACAAGACGGAG GAAGGCGGGGATGACGTCAAATCATCATGCCCCTTATGACCTGGGCTACACACGTGCTACAATGGTTGGTACAACGGGATGCTACC TCGCGAGAGGACGCCAATCTCTTAAAACCAATCTCAGTTCGGATTGTAGGCTGCAACTCGCCTACATGAAGTCGGAATCGCTAGTA ATCGCGGATCAGCATGCCGCGGTGAATACGTTCCCGGGCCTTGTACACACCGCCCGTCACACCACGGGAGTTTGCAACACCCGAAG TCGGTGAGGTAACCGCAAGGAGCCAG |
| Strain Morphology Photos | |
| Morphological Description | Colony round;clam white;edge neatly;Slightly convex on the edge;Slightly convex in the middle;multifold;slippy;sticky;Waxed;Rod;having spore;Mesophilic budding spore |